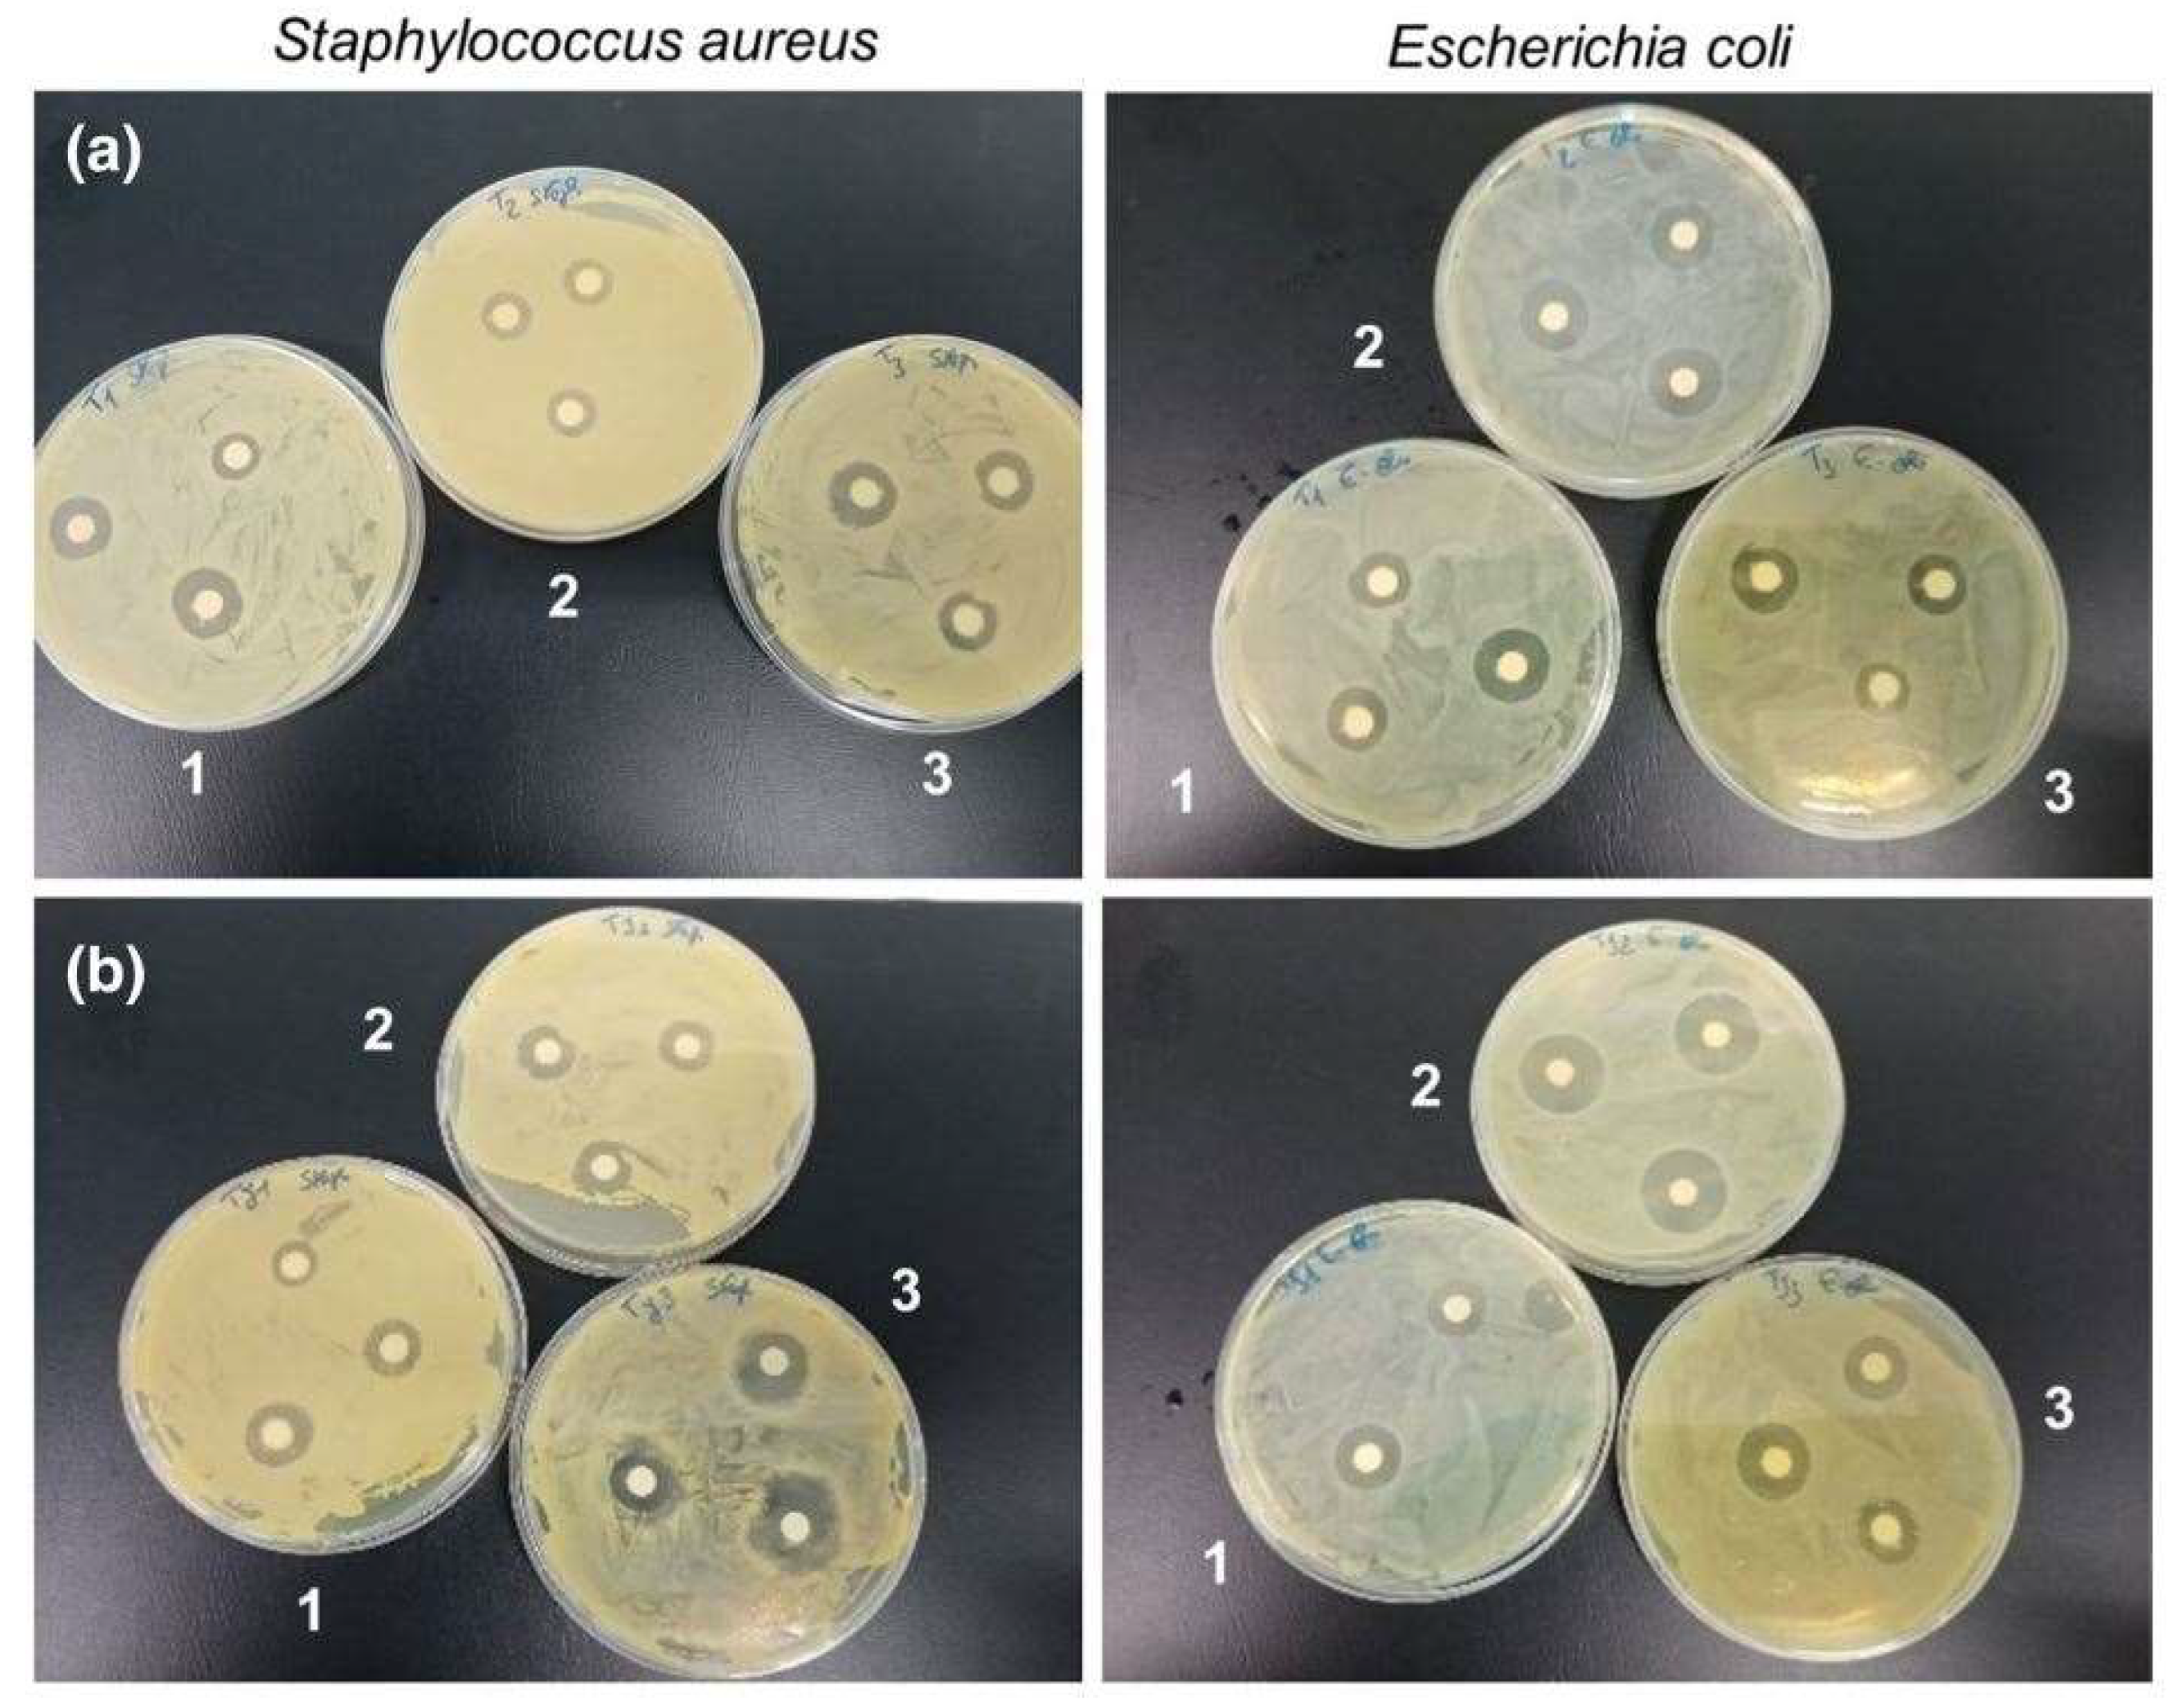

Wetspun Polymeric Fibrous Systems as Potential Scaffolds for Tendon and Ligament Repair, Healing and Regeneration
Abstract
1. Introduction
2. Tendon and Ligaments
2.1. Structure, Composition, and Biomechanics
2.2. Treatment Strategies
3. Wetspinning
Process Parameters
4. Biodegradable Polymers
5. Wetspun Nanofibers as Scaffolds for Tendon and Ligament Repair, Healing and Regeneration
5.1. Polyhydroxyalkanoates (PHAs)
5.2. Polycaprolactone (PCL)
5.3. Polyethylenes
6. Incorporation of Reinforcing Agents
6.1. Cellulose Nanocrystals (CNC)
6.2. Nanoparticles
6.3. Growth Factors
7. Spinning
8. Conclusions and Perspectives
Author Contributions
Funding
Conflicts of Interest
References
- Rinoldi, C.; Kijeńska-Gawrońska, E.; Khademhosseini, A.; Tamayol, A.; Swieszkowski, W. Fibrous Systems as Potential Solutions for Tendon and Ligament Repair, Healing, and Regeneration. Adv. Healthc. Mater. 2021, 10, 2001305. [Google Scholar] [CrossRef] [PubMed]
- Ruiz-Alonso, S.; Lafuente-Merchan, M.; Ciriza, J.; Saenz-del-Burgo, L.; Pedraz, J.L. Tendon tissue engineering: Cells, growth factors, scaffolds and production techniques. J. Control. Release 2021, 333, 448–486. [Google Scholar] [CrossRef]
- Steinmann, S.; Pfeifer, C.G.; Brochhausen, C.; Docheva, D. Spectrum of tendon pathologies: Triggers, trails and end-state. Int. J. Mol. Sci. 2020, 21, 844. [Google Scholar] [CrossRef] [PubMed]
- Ratcliffe, A.; Butler, D.L.; Dyment, N.A.; Cagle, P.J.; Proctor, C.S.; Ratcliffe, S.S.; Flatow, E.L. Scaffolds for Tendon and Ligament Repair and Regeneration. Ann. Biomed. Eng. 2015, 43, 819–831. [Google Scholar] [CrossRef]
- Wang, T.; Gardiner, B.S.; Lin, Z.; Rubenson, J.; Kirk, T.B.; Wang, A.; Xu, J.; Smith, D.W.; Lloyd, D.G.; Zheng, M.H. Bioreactor design for tendon/ligament engineering. Tissue Eng. Part B Rev. 2013, 19, 133–146. [Google Scholar] [CrossRef] [PubMed]
- Clark, S.T.; Zhu, M.; Gamble, G.D.; Naot, D.; Paine, S.J.; Dalbeth, N.; Cornish, J.; Musson, D.S. Epidemiology of tendon and ligament injuries in Aotearoa/New Zealand between 2010 and 2016. Inj. Epidemiol. 2020, 7, 5. [Google Scholar] [CrossRef]
- Paredes, J.J.; Andarawis-Puri, N. Therapeutics for tendon regeneration: A multidisciplinary review of tendon research for improved healing. Ann. N. Y. Acad. Sci. USA 2016, 1383, 125–138. [Google Scholar] [CrossRef]
- Manent, A.; López, L.; Coromina, H.; Santamaría, A.; Domínguez, A.; Llorens, N.; Sales, M.; Videla, S. Acute Achilles Tendon Ruptures: Efficacy of Conservative and Surgical (Percutaneous, Open) Treatment—A Randomized, Controlled, Clinical Trial. J. Foot Ankle Surg. 2019, 58, 1229–1234. [Google Scholar] [CrossRef]
- Kauwe, M. Acute Achilles Tendon Rupture: Clinical Evaluation, Conservative Management, and Early Active Rehabilitation. Clin. Podiatr. Med. Surg. 2017, 34, 229–243. [Google Scholar] [CrossRef]
- Linderman, S.W.; Shen, H.; Yoneda, S.; Jayaram, R.; Tanes, M.L.; Sakiyama-Elbert, S.E.; Xia, Y.; Thomopoulos, S.; Gelberman, R.H. Effect of connective tissue growth factor delivered via porous sutures on the proliferative stage of intrasynovial tendon repair. J. Orthop. Res. 2018, 36, 2052–2063. [Google Scholar] [CrossRef]
- Prabhath, A.; Vernekar, V.N.; Sanchez, E.; Laurencin, C.T. Growth factor delivery strategies for rotator cuff repair and regeneration. Int. J. Pharm. 2018, 544, 358–371. [Google Scholar] [CrossRef]
- Tang, J.B.; Zhou, Y.L.; Wu, Y.F.; Liu, P.Y.; Wang, X.T. Gene therapy strategies to improve strength and quality of flexor tendon healing. Expert Opin. Biol. Ther. 2016, 16, 291–301. [Google Scholar] [CrossRef]
- Graham, J.G.; Wang, M.L.; Rivlin, M.; Beredjiklian, P.K. Biologic and mechanical aspects of tendon fibrosis after injury and repair. Connect. Tissue Res. 2019, 60, 10–20. [Google Scholar] [CrossRef]
- Hardy, A.; Rousseau, R.; Issa, S.P.; Gerometta, A.; Pascal-Moussellard, H.; Granger, B.; Khiami, F. Functional outcomes and return to sports after surgical treatment of insertional Achilles tendinopathy: Surgical approach tailored to the degree of tendon involvement. Orthop. Traumatol. Surg. Res. 2018, 104, 719–723. [Google Scholar] [CrossRef]
- Lewington, M.R.; Ferguson, D.P.; Smith, T.D.; Burks, R.; Coady, C.; Wong, I.H.B. Graft Utilization in the Bridging Reconstruction of Irreparable Rotator Cuff Tears: A Systematic Review. Am. J. Sports Med. 2017, 45, 3149–3157. [Google Scholar] [CrossRef]
- Coons, D.A.; Alan Barber, F. Tendon graft substitutes—Rotator cuff patches. Sports Med. Arthrosc. 2006, 14, 185–190. [Google Scholar] [CrossRef]
- Constantinescu, D.S.; Campbell, M.P.; Moatshe, G.; Vap, A.R. Effects of Perioperative Nonsteroidal Anti-inflammatory Drug Administration on Soft Tissue Healing: A Systematic Review of Clinical Outcomes After Sports Medicine Orthopaedic Surgery Procedures. Orthop. J. Sport. Med. 2019, 7, 2325967119838873. [Google Scholar] [CrossRef] [PubMed]
- Kane, S.F.; Olewinski, L.H.; Tamminga, K.S. Management of Chronic Tendon Injuries; American Academy of Family Physicians: Leawood, KS, USA, 2019; Volume 100. [Google Scholar]
- Cao, Y.; Liu, Y.; Liu, W.; Shan, Q.; Buonocore, S.D.; Chui, L. Bridging Tendon Defects Using Autologous Tenocyte Engineered Tendon in a Hen Model. Plast. Reconstr. Surg. 2002, 110, 1280–1289. [Google Scholar] [PubMed]
- Sharma, P.; Kumar, P.; Sharma, R.; Bhatt, V.D.; Dhot, P.S. Tissue Engineering; Current Status & Futuristic Scope. J. Med. Life 2019, 12, 225–229. [Google Scholar] [PubMed]
- Langer, R.; Vacanti, J.P. Tissue Engineering. Educ. Forum 1993, 260, 920–926. [Google Scholar] [CrossRef]
- Puppi, D.; Dinucci, D.; Bartoli, C.; Mota, C.; Migone, C.; Dini, F.; Barsotti, G.; Carlucci, F.; Chiellini, F. Development of 3D wet-spun polymeric scaffolds loaded with antimicrobial agents for bone engineering. J. Bioact. Compat. Polym. 2011, 26, 478–492. [Google Scholar] [CrossRef]
- Rinoldi, C.; Costantini, M.; Kijeńska-Gawrońska, E.; Testa, S.; Fornetti, E.; Heljak, M.; Ćwiklińska, M.; Buda, R.; Baldi, J.; Cannata, S.; et al. Tendon Tissue Engineering: Effects of Mechanical and Biochemical Stimulation on Stem Cell Alignment on Cell-Laden Hydrogel Yarns. Adv. Healthc. Mater. 2019, 8, 1801218. [Google Scholar] [CrossRef] [PubMed]
- Abay Akar, N.; Gürel Peközer, G.; Torun Köse, G. Fibrous bone tissue engineering scaffolds prepared by wet spinning of PLGA. Turk. J. Biol. 2019, 43, 235–245. [Google Scholar] [CrossRef] [PubMed]
- Song, R.; Murphy, M.; Li, C.; Ting, K.; Soo, C.; Zheng, Z. Current development of biodegradable polymeric materials for biomedical applications. Drug Des. Devel. Ther. 2018, 12, 3117–3145. [Google Scholar] [CrossRef] [PubMed]
- Tarrahi, R.; Fathi, Z.; Seydibeyoğlu, M.Ö.; Doustkhah, E.; Khataee, A. Polyhydroxyalkanoates (PHA): From production to nanoarchitecture. Int. J. Biol. Macromol. 2020, 146, 596–619. [Google Scholar] [CrossRef]
- Niinivaara, E.; Cranston, E.D. Bottom-up assembly of nanocellulose structures. Carbohydr. Polym. 2020, 247, 116664. [Google Scholar] [CrossRef]
- Domingues, R.M.A.; Chiera, S.; Gershovich, P.; Motta, A.; Reis, R.L.; Gomes, M.E. Enhancing the Biomechanical Performance of Anisotropic Nanofibrous Scaffolds in Tendon Tissue Engineering: Reinforcement with Cellulose Nanocrystals. Adv. Healthc. Mater. 2016, 5, 1364–1375. [Google Scholar] [CrossRef]
- Parchi, P.D.; Vittorio, O.; Andreani, L.; Battistini, P.; Piolanti, N.; Marchetti, S.; Poggetti, A.; Lisanti, M. Nanoparticles for tendon healing and regeneration: Literature review. Front. Aging Neurosci. 2016, 8, 202. [Google Scholar] [CrossRef]
- Araújo, J.C.; Fangueiro, R. Protective Multifunctional Fibrous Systems Based on Natural Fibers and Metal Oxide Nanoparticles. Polymers 2021, 13, 2654. [Google Scholar] [CrossRef]
- Costa, S.M.; Ferreira, D.P.; Ferreira, A.; Vaz, F.; Fangueiro, R. Multifunctional flax fibres based on the combined effect of silver and zinc oxide (Ag/ZnO) nanostructures. Nanomaterials 2018, 8, 1069. [Google Scholar] [CrossRef]
- Costa, S.M.; Antunes, W.; Vieira, R.; Bem, N.; Teixeira, P.; Fangueiro, R.; Ferreira, D.P. Antibacterial and Biodegradable Electrospun Filtering Membranes for Facemasks: An Attempt to Reduce Disposable Masks Use. Appl. Sci. 2022, 12, 67. [Google Scholar] [CrossRef]
- Araújo, J.C.; Ferreira, D.P.; Teixeira, P.; Fangueiro, R. In-situ synthesis of CaO and SiO2 nanoparticles onto jute fabrics: Exploring the multifunctionality. Cellulose 2021, 28, 1123–1138. [Google Scholar] [CrossRef]
- Araújo, J.C.; Teixeira, P.; Fanueiro, R.; Ferreira, D.P. Multifunctional natural fibers: The potential of core shell MgO–SiO2 nanoparticles. Cellulose 2022, 29, 5659–5676. [Google Scholar] [CrossRef]
- Laurencin, C.T.; Freeman, J.W. Ligament tissue engineering: An evolutionary materials science approach. Biomaterials 2005, 26, 7530–7536. [Google Scholar] [CrossRef] [PubMed]
- Asahara, H.; Inui, M.; Lotz, M.K. Tendons and Ligaments: Connecting Developmental Biology to Musculoskeletal Disease Pathogenesis. J. Bone Miner. Res. 2017, 32, 1773–1782. [Google Scholar] [CrossRef] [PubMed]
- Reese, S.P.; Maas, S.A.; Weiss, J.A. Micromechanical models of helical superstructures in ligament and tendon fibers predict large Poisson’s ratios. J. Biomech. 2010, 43, 1394–1400. [Google Scholar] [CrossRef] [PubMed]
- James, R.; Kesturu, G.; Balian, G.; Chhabra, A.B. Tendon: Biology, Biomechanics, Repair, Growth Factors, and Evolving Treatment Options. J. Hand Surg. Am. 2008, 33, 102–112. [Google Scholar] [CrossRef]
- Wang, J.H.C. Mechanobiology of tendon. J. Biomech. 2006, 39, 1563–1582. [Google Scholar] [CrossRef]
- Van Leeuwen, M.T.; Zwerver, J.; van den Akker-Scheek, I. Extracorporeal Shockwave therapy for patellar tendinopathy: A review of the literature. Br. J. Sports Med. 2009, 43, 163–168. [Google Scholar] [CrossRef]
- Notarnicola, A.; Moretti, B. The biological effects of extracorporeal shock wave therapy (eswt) on tendon tissue. Muscles Ligaments Tendons J. 2012, 2, 33–37. [Google Scholar]
- Liao, S.; Murugan, R.; Chan, C.K.; Ramakrishna, S. Processing nanoengineered scaffolds through electrospinning and mineralization suitable for biomimetic bone tissue engineering. J. Mech. Behav. Biomed. Mater. 2008, 1, 252–260. [Google Scholar] [CrossRef] [PubMed]
- Vieira, A.C.; Guedes, R.M.; Marques, A.T. Development of ligament tissue biodegradable devices: A review. J. Biomech. 2009, 42, 2421–2430. [Google Scholar] [CrossRef] [PubMed]
- Lipman, K.; Wang, C.; Ting, K.; Soo, C.; Zheng, Z. Tendinopathy: Injury, repair, and current exploration. Drug Des. Devel. Ther. 2018, 12, 591–603. [Google Scholar] [CrossRef]
- Langberg, H.; Ellingsgaard, H.; Madsen, T.; Jansson, J.; Magnusson, S.P.; Aagaard, P.; Kjær, M. Eccentric rehabilitation exercise increases peritendinous type I collagen synthesis in humans with Achilles tendinosis. Scand. J. Med. Sci. Sports 2007, 17, 61–66. [Google Scholar] [CrossRef]
- Rodrigues, M.T.; Reis, R.L.; Gomes, M.E. Engineering tendon and ligament tissues: Present develpments towards successful clinical products. Tissue Eng. Regen. Med. 2013, 7, 673–686. [Google Scholar] [CrossRef]
- Sigal, I.R.; Grande, D.A.; Dines, D.M.; Dines, J.; Drakos, M. Biologic and Tissue Engineering Strategies for Tendon Repair. Regen. Eng. Transl. Med. 2016, 2, 107–125. [Google Scholar] [CrossRef]
- Anastasiou, E.; Lorentz, K.O.; Stein, G.J.; Mitchell, P.D. Prehistoric schistosomiasis parasite found in the Middle East. Lancet Infect. Dis. 2014, 14, 553–554. [Google Scholar] [CrossRef]
- Fallon, K.; Purdam, C.; Cook, J.; Lovell, G. A “polypill” for acute tendon pain in athletes with tendinopathy? J. Sci. Med. Sport 2008, 11, 235–238. [Google Scholar] [CrossRef]
- Ferry, S.T.; Dahners, L.E.; Afshari, H.M.; Weinhold, P.S. The effects of common anti-inflammatory drugs on the healing rat patellar tendon. Am. J. Sports Med. 2007, 35, 1326–1333. [Google Scholar] [CrossRef]
- Berardi, A.C. (Ed.) Extracellular Matrix for Tissue Engineering and Biomaterials; Stem Cell Biology and Regenerative Medicine; Humana Press: New York, NY, USA, 2018. [Google Scholar]
- Lui, P.P.Y.; Ng, S.W. Cell therapy for the treatment of tendinopathy—A systematic review on the pre-clinical and clinical evidence. Semin. Arthritis Rheum. 2013, 42, 651–666. [Google Scholar] [CrossRef]
- Smith, R.K.W. Cell-based therapies for the repair and regeneration of tendons and ligaments. Regen. Med. Biomater. Repair Connect. Tissues 2010, 436–451. [Google Scholar]
- Mehrzad, R.; Wang, X.T.; Zhou, Y.L.; Wu, Y.F.; Liu, P.Y. Gene therapy in Tendon Repair and Regeneration. In Gene Therapy in Reconstructive and Regenerative Surgery; Springer: Cham, Switzerland, 2018. [Google Scholar]
- Skjong, C.C.; Meininger, A.K.; Ho, S.S.W. Tendinopathy Treatment: Where is the Evidence? Clin. Sports Med. 2012, 31, 329–350. [Google Scholar] [CrossRef] [PubMed]
- Armitage, O.E.; Oyen, M.L. Hard-soft tissue interface engineering. Adv. Exp. Med. Biol. 2015, 881, 187–204. [Google Scholar]
- Andarawis-Puri, N.; Flatow, E.L.; Soslowsky, L.J. Tendon basic science: Development, repair, regeneration, and healing. J. Orthop. Res. 2015, 33, 780–784. [Google Scholar] [CrossRef]
- Calejo, I.; Costa-Almeida, R.; Reis, R.L.; Gomes, M.E. A Textile Platform Using Continuous Aligned and Textured Composite Microfibers to Engineer Tendon-to-Bone Interface Gradient Scaffolds. Adv. Healthc. Mater. 2019, 8, 1900200. [Google Scholar] [CrossRef] [PubMed]
- Puppi, D.; Chiellini, F.; Chemistry, I. Wet-spinning of Biomedical Polymers: From Single Fibers Production to Additive Manufacturing of 3D Scaffolds. Polym. Int. 2017, 66, 1690–1696. [Google Scholar] [CrossRef]
- DeFrates, K.G.; Moore, R.; Borgesi, J.; Lin, G.; Mulderig, T.; Beachley, V.; Hu, X. Protein-based fiber materials in medicine: A review. Nanomaterials 2018, 8, 457. [Google Scholar] [CrossRef] [PubMed]
- Funakoshi, T.; Majima, T.; Iwasaki, N.; Yamane, S.; Masuko, T.; Minami, A.; Harada, K.; Tamura, H.; Tokura, S.; Nishimura, S.I. Novel chitosan-based hyaluronan hybrid polymer fibers as a scaffold in ligament tissue engineering. J. Biomed. Mater. Res. Part A 2005, 74, 338–346. [Google Scholar] [CrossRef] [PubMed]
- Vehviläinen, M.; Kamppuri, T.; Rom, M.; Janicki, J.; Ciechańska, D.; Grönqvist, S.; Siika-Aho, M.; Christoffersson, K.E.; Nousiainen, P. Effect of wet spinning parameters on the properties of novel cellulosic fibres. Cellulose 2008, 15, 671–680. [Google Scholar] [CrossRef]
- Costa, S.M.; Fangueiro, R.; Ferreira, D.P. Drug Delivery Systems for Photodynamic Therapy: The Potentiality and Versatility of Electrospun Nanofibers. Macromol. Biosci. 2022, 22, 2100512. [Google Scholar] [CrossRef]
- Singhi, B.; Ford, E.N.; King, M.W. The effect of wet spinning conditions on the structure and properties of poly-4-hydroxybutyrate fibers. J. Biomed. Mater. Res. Part B Appl. Biomater. 2021, 109, 982–989. [Google Scholar] [CrossRef]
- Miranda, C.S.; Silva, A.F.G.; Pereira-Lima, S.M.M.A.; Costa, S.P.G.; Homem, N.C.; Felgueiras, H.P. Tunable Spun Fiber Constructs in Biomedicine: Influence of Processing Parameters in the Fibers’ Architecture. Pharmaceutics 2022, 14, 164. [Google Scholar] [CrossRef] [PubMed]
- Nair, L.S.; Laurencin, C.T. Biodegradable polymers as biomaterials. Prog. Polym. Sci. 2007, 32, 762–798. [Google Scholar] [CrossRef]
- Li, Z.; Yang, J.; Loh, X.J. Polyhydroxyalkanoates: Opening doors for a sustainable future. NPG Asia Mater. 2016, 8, e265. [Google Scholar] [CrossRef]
- Mogoşanu, G.D.; Grumezescu, A.M. Natural and synthetic polymers for wounds and burns dressing. Int. J. Pharm. 2014, 463, 127–136. [Google Scholar] [CrossRef] [PubMed]
- Chandra, S. Natural and Synthetic Polymers. In Polymers in Concrete; CRC Press: Boca Raton, FL, USA, 2020; pp. 5–25. [Google Scholar]
- Domingues, R.M.A.; Gomes, M.E.; Reis, R.L. The potential of cellulose nanocrystals in tissue engineering strategies. Biomacromolecules 2014, 15, 2327–2346. [Google Scholar] [CrossRef] [PubMed]
- Mármol, G.; Gauss, C.; Fangueiro, R. Potential of cellulose microfibers for PHA and PLA biopolymers reinforcement. Molecules 2020, 25, 4653. [Google Scholar] [CrossRef]
- Puppi, D.; Pecorini, G.; Chiellini, F. Biomedical processing of polyhydroxyalkanoates. Bioengineering 2019, 6, 108. [Google Scholar] [CrossRef]
- Doyle, C.; Tanner, E.T.; Bonfield, W. In vitro and in vivo evaluation of polyhydroxybutyrate and of polyhydroxybutyrate reinforced with hydroxyapatite. Biomaterials 1991, 12, 841–847. [Google Scholar] [CrossRef]
- Ni, J.; Wang, M. In vitro evaluation of hydroxyapatite reinforced polyhydroxybutyrate composite. Mater. Sci. Eng. C 2002, 20, 101–109. [Google Scholar] [CrossRef]
- Degeratu, C.N.; Mabilleau, G.; Aguado, E.; Mallet, R.; Chappard, D.; Cincu, C.; Stancu, I.C. Polyhydroxyalkanoate (PHBV)fibers obtained by a wet spinning method: Good in vitro cytocompatibility but absence of in vivo biocompatibility when used as a bone graft. Morphologie 2019, 103, 94–102. [Google Scholar] [CrossRef] [PubMed]
- Alagoz, A.S.; Rodriguez-Cabello, J.C.; Hasirci, V. PHBV wet spun scaffold coated with ELR-REDV improves vascularization for bone tissue engineering. Biomed. Mater. 2018, 13, 055010. [Google Scholar] [CrossRef]
- Puppi, D.; Chiellini, F.; Piras, A.M.; Chiellini, E. Polymeric materials for bone and cartilage repair. Prog. Polym. Sci. 2010, 35, 403–440. [Google Scholar] [CrossRef]
- Zhao, K.; Deng, Y.; Chen, J.C.; Chen, G.Q. Polyhydroxyalkanoate (PHA) scaffolds with good mechanical properties and biocompatibility. Biomaterials 2003, 24, 1041–1045. [Google Scholar] [CrossRef]
- Wang, Y.; Bian, Y.Z.; Wu, Q.; Chen, G.Q. Evaluation of three-dimensional scaffolds prepared from poly(3-hydroxybutyrate-co-3-hydroxyhexanoate) for growth of allogeneic chondrocytes for cartilage repair in rabbits. Biomaterials 2008, 29, 2858–2868. [Google Scholar] [CrossRef]
- Deng, Y.; Zhao, K.; Zhang, X.F.; Hu, P.; Chen, G.Q. Study on the three-dimensional proliferation of rabbit articular cartilage-derived chondrocytes on polyhydroxyalkanoate scaffolds. Biomaterials 2002, 23, 4049–4056. [Google Scholar] [CrossRef]
- Deng, Y.; Lin, X.S.; Zheng, Z.; Deng, J.G.; Chen, J.C.; Ma, H.; Chen, G.Q. Poly(hydroxybutyrate-co-hydroxyhexanoate) promoted production of extracellular matrix of articular cartilage chondrocytes in vitro. Biomaterials 2003, 24, 4273–4281. [Google Scholar] [CrossRef]
- Ik, S.L.; Oh, H.K.; Meng, W.; Kang, I.K.; Ito, Y. Nanofabrication of microbial polyester by electrospinning promotes cell attachment. Macromol. Res. 2004, 12, 374–378. [Google Scholar]
- Puppi, D.; Mota, C.; Gazzarri, M.; Dinucci, D.; Gloria, A.; Myrzabekova, M.; Ambrosio, L.; Chiellini, F. Additive manufacturing of wet-spun polymeric scaffolds for bone tissue engineering. Biomed. Microdevices 2012, 14, 1115–1127. [Google Scholar] [CrossRef] [PubMed]
- Puppi, D.; Pirosa, A.; Lupi, G.; Erba, P.A.; Giachi, G.; Chiellini, F. Design and fabrication of novel polymeric biodegradable stents for small caliber blood vessels by computer-aided wet-spinning. Biomed. Mater. 2017, 12, 035011. [Google Scholar] [CrossRef] [PubMed]
- Azimi, B.; Nourpanah, P.; Rabiee, M.; Arbab, S. Poly (ε-caprolactone) fiber: An overview. J. Eng. Fiber. Fabr. 2014, 9, 74–90. [Google Scholar]
- Guarino, V.; Gentile, G.; Sorrentino, L.; Ambrosio, L. Polycaprolactone: Synthesis, Properties, and Applications. In Encyclopedia of Polymer Science and Technology; John Wiley & Sons, Inc.: Hoboken, NJ, USA, 2017. [Google Scholar]
- Wu, G.; Deng, X.; Song, J.; Chen, F. Enhanced biological properties of biomimetic apatite fabricated polycaprolactone/chitosan nanofibrous bio-composite for tendon and ligament regeneration. J. Photochem. Photobiol. B Biol. 2018, 178, 27–32. [Google Scholar] [CrossRef] [PubMed]
- Wang, L.; Zhang, J.; Wang, L.; Zhu, M.; Xiao, N.; Kong, D. Wet-spun poly(ε-caprolactone) microfiber scaffolds for oriented growth and infiltration of smooth muscle cells. Mater. Lett. 2014, 132, 59–62. [Google Scholar] [CrossRef]
- Williamson, M.R.; Coombes, A.G.A. Gravity spinning of polycaprolactone fibres for applications in tissue engineering. Biomaterials 2004, 25, 459–465. [Google Scholar] [CrossRef]
- Puppi, D.; Piras, A.M.; Chiellini, F.; Chiellini, E.; Martins, A.; Leonor, I.B.; Neves, N.; Reis, R. Optimized electro- and wet-spinning techniques for the production of polymeric fibrous scaffolds loaded with bisphosphonate and hydroxyapatite. J. Tissue Eng. Regen. Med. 2010, 5, 253–263. [Google Scholar] [CrossRef]
- Neves, S.C.; Moreira Teixeira, L.S.; Moroni, L.; Reis, R.L.; van Blitterswijk, C.A.; Alves, N.M.; Karperien, M.; Mano, J.F. Chitosan/Poly(ɛ-caprolactone) blend scaffolds for cartilage repair. Biomaterials 2011, 32, 1068–1079. [Google Scholar] [CrossRef] [PubMed]
- Knop, K.; Hoogenboom, R.; Fischer, D.; Schubert, U.S. Poly(ethylene glycol) in drug delivery: Pros and cons as well as potential alternatives. Angew. Chem. Int. Ed. 2010, 49, 6288–6308. [Google Scholar] [CrossRef]
- Parra, D.F.; Fusaro, J.; Gaboardi, F.; Rosa, D.S. Influence of poly (ethylene glycol) on the thermal, mechanical, morphological, physical-chemical and biodegradation properties of poly (3-hydroxybutyrate). Polym. Degrad. Stab. 2006, 91, 1954–1959. [Google Scholar] [CrossRef]
- D’souza, A.A.; Shegokar, R. Polyethylene glycol (PEG): A versatile polymer for pharmaceutical applications. Expert Opin. Drug Deliv. 2016, 13, 1257–1275. [Google Scholar] [CrossRef]
- Gamba, A.M.; Fonseca, J.S.; Méndez, D.A.; Viloria, A.; Fajardo, D.; Moreno, N.C.; Cabeza, I.O. Assessment of different plasticizer—Polyhydroxyalkanoate mixtures to obtain biodegradable polymeric films. Chem. Eng. Trans. 2017, 57, 1363–1368. [Google Scholar]
- Pivsa-Art, W.; Fujii, K.; Nomura, K.; Aso, Y.; Ohara, H.; Yamane, H. The effect of poly(ethylene glycol) as plasticizer in blends of poly(lactic acid) and poly(butylene succinate). J. Appl. Polym. Sci. 2016, 133, 43044. [Google Scholar] [CrossRef]
- Panaitescu, D.M.; Nicolae, C.A.; Frone, A.N.; Chiulan, I.; Stanescu, P.O.; Draghici, C.; Iorga, M.; Mihailescu, M. Plasticized poly(3-hydroxybutyrate) with improved melt processing and balanced properties. J. Appl. Polym. Sci. 2017, 134, 44810. [Google Scholar] [CrossRef]
- Lu, T.; Hu, H.; Li, Y.; Jiang, Q.; Su, J.; Lin, H.; Xiao, Y.; Zhu, X.; Zhang, X. Bioactive scaffolds based on collagen filaments with tunable physico-chemical and biological features. Soft Matter 2020, 16, 4540–4548. [Google Scholar] [CrossRef] [PubMed]
- Nofar, M. Polyethylene glycol. In Multiphase Polylactide Blends; Elsevier: Amsterdam, The Netherlands, 2021; Volume 18, pp. 233–263. [Google Scholar]
- Kariduraganavar, M.Y.; Kittur, A.A.; Kamble, R.R. Polymer Synthesis and Processing. In Natural and Synthetic Biomedical Polymers; Elsevier: Amsterdam, The Netherlands, 2014; pp. 1–31. [Google Scholar]
- Lima, R.B. Nanofibras de Materiais Biológicos. Ph.D. Thesis, University of Minho, Guimarães, Portugal, 2013. [Google Scholar]
- Son, W.K.; Youk, J.H.; Lee, T.S.; Park, W.H. The effects of solution properties and polyelectrolyte on electrospinning of ultrafine poly(ethylene oxide) fibers. Polymer 2004, 45, 2959–2966. [Google Scholar] [CrossRef]
- Kianfar, P.; Vitale, A.; Dalle Vacche, S.; Bongiovanni, R. Photo-crosslinking of chitosan/poly(ethylene oxide) electrospun nanofibers. Carbohydr. Polym. 2019, 217, 144–151. [Google Scholar] [CrossRef] [PubMed]
- Wang, D.; Cheng, W.; Wang, Q.; Zang, J.; Zhang, Y.; Han, G. Preparation of electrospun chitosan/poly(ethylene oxide) composite nanofibers reinforced with cellulose nanocrystals: Structure, morphology, and mechanical behavior. Compos. Sci. Technol. 2019, 182, 107774. [Google Scholar] [CrossRef]
- Righi, T.M.; Almeida, R.S.; D’Ávila, M.A. Electrospinning of gelatin/PEO blends: Influence of process parameters in the nanofiber properties. Macromol. Symp. 2012, 319, 230–234. [Google Scholar] [CrossRef]
- Cui, Q.; Bell, D.J.; Rauer, S.B.; Wessling, M. Wet-Spinning of Biocompatible Core–Shell Polyelectrolyte Complex Fibers for Tissue Engineering. Adv. Mater. Interfaces 2020, 7, 2000849. [Google Scholar] [CrossRef]
- Wang, Y.; Chen, H. Toughen and Strengthen Alginate Fiber by Incorporation of Polyethylene Glycol Grafted Cellulose Nanocrystals. Cellulose 2021, 29, 5021–5035. [Google Scholar] [CrossRef]
- Arafat, M.T.; Tronci, G.; Yin, J.; Wood, D.J.; Russell, S.J. Biomimetic wet-stable fibres via wet spinning and diacid-based crosslinking of collagen triple helices. Polymer 2015, 77, 102–112. [Google Scholar] [CrossRef]
- Sharma, A.; Thakur, M.; Bhattacharya, M.; Mandal, T.; Goswami, S. Commercial application of cellulose nano-composites—A review. Biotechnol. Rep. 2019, 21, e00316. [Google Scholar] [CrossRef] [PubMed]
- Vatansever, E.; Arslan, D.; Nofar, M. Polylactide cellulose-based nanocomposites. Int. J. Biol. Macromol. 2019, 137, 912–938. [Google Scholar] [CrossRef] [PubMed]
- Gopi, S.; Balakrishnan, P.; Chandradhara, D.; Poovathankandy, D.; Thomas, S. General scenarios of cellulose and its use in the biomedical field. Mater. Today Chem. 2019, 13, 59–78. [Google Scholar] [CrossRef]
- Grishkewich, N.; Mohammed, N.; Tang, J.; Tam, K.C. Recent advances in the application of cellulose nanocrystals. Curr. Opin. Colloid Interface Sci. 2017, 29, 32–45. [Google Scholar] [CrossRef]
- Karimian, A.; Parsian, H.; Majidinia, M.; Rahimi, M.; Mir, S.M.; Samadi Kafil, H.; Shafiei-Irannejad, V.; Kheyrollah, M.; Ostadi, H.; Yousefi, B. Nanocrystalline cellulose: Preparation, physicochemical properties, and applications in drug delivery systems. Int. J. Biol. Macromol. 2019, 133, 850–859. [Google Scholar] [CrossRef] [PubMed]
- Iwamoto, S.; Isogai, A.; Iwata, T. Structure and mechanical properties of wet-spun fibers made from natural cellulose nanofibers. Biomacromolecules 2011, 12, 831–836. [Google Scholar] [CrossRef]
- Sheng, L.; Jiang, R.; Zhu, Y.; Ji, Y. Electrospun cellulose nanocrystals/polycaprolactone nanocomposite fiber mats. J. Macromol. Sci. Part B Phys. 2014, 53, 820–828. [Google Scholar] [CrossRef]
- Uddin, A.J.; Araki, J.; Gotoh, Y. Toward “Strong” Green Nanocomposites: Polyvinyl alcohol reinforced with extremely oriented cellulose whiskers. Biomacromolecules 2011, 12, 617–624. [Google Scholar] [CrossRef]
- Park, J.S.; Park, C.W.; Han, S.Y.; Lee, E.A.; Cindradewi, A.W.; Kim, J.K.; Kwon, G.J.; Seo, Y.H.; Youe, W.J.; Gwon, J.; et al. Preparation and Properties of Wet-Spun Microcomposite Filaments from Cellulose Nanocrystals and Alginate Using a Microfluidic Device. BioResources 2021, 16, 5780–5793. [Google Scholar] [CrossRef]
- Liu, J.; Zhang, R.; Ci, M.; Sui, S.; Zhu, P. Sodium alginate/cellulose nanocrystal fibers with enhanced mechanical strength prepared by wet spinning. J. Eng. Fiber. Fabr. 2019, 14, 1558925019847553. [Google Scholar] [CrossRef]
- Silva, M.; Ferreira, F.N.; Alves, N.M.; Paiva, M.C. Biodegradable polymer nanocomposites for ligament/tendon tissue engineering. J. Nanobiotechnology 2020, 18, 23. [Google Scholar] [CrossRef] [PubMed]
- Ferreira, D.P.; Ferreira, A.; Fangueiro, R. Searching for natural conductive fibrous structures via a green sustainable approach based on jute fibers and silver nanoparticles. Polymers 2018, 10, 63. [Google Scholar] [CrossRef] [PubMed]
- Kwan, K.H.L.; Yeung, K.W.K.; Liu, X.; Wong, K.K.Y.; Shum, H.C.; Lam, Y.W.; Cheng, S.H.; Cheung, K.M.C.; To, M.K.T. Silver nanoparticles alter proteoglycan expression in the promotion of tendon repair. Nanomed. Nanotechnol. Biol. Med. 2014, 10, 1375–1383. [Google Scholar] [CrossRef] [PubMed]
- Kolathupalayam Shanmugam, B.; Rangaraj, S.; Subramani, K.; Srinivasan, S.; Aicher, W.K.; Venkatachalam, R. Biomimetic TiO2-chitosan/sodium alginate blended nanocomposite scaffolds for tissue engineering applications. Mater. Sci. Eng. C 2020, 110, 110710. [Google Scholar] [CrossRef]
- Gross, G.; Hoffmann, A. Therapeutic strategies for tendon healing based on novel biomaterials, factors and cells. Pathobiology 2013, 80, 203–210. [Google Scholar] [CrossRef]
- Rajpar, I.; Barrett, J.G. Optimizing growth factor induction of tenogenesis in three-dimensional culture of mesenchymal stem cells. J. Tissue Eng. 2019, 10, 2041731419848776. [Google Scholar] [CrossRef]
- Evrova, O.; Bürgisser, G.M.; Ebnöther, C.; Adathala, A.; Calcagni, M.; Bachmann, E.; Snedeker, J.G.; Scalera, C.; Giovanoli, P.; Vogel, V.; et al. Elastic and surgeon friendly electrospun tubes delivering PDGF-BB positively impact tendon rupture healing in a rabbit Achilles tendon model. Biomaterials 2020, 232, 119722. [Google Scholar] [CrossRef]
- Durgam, S.S.; Stewart, A.A.; Pondenis, H.C.; Gutierrez-Nibeyro, S.M.; Evans, R.B.; Stewart, M.C. Comparison of equine tendon-and bone marrow-derived cells cultured on tendon matrix with or without insulin-like growth factor-I supplementation. Am. J. Vet. Res. 2012, 73, 153–161. [Google Scholar] [CrossRef]
- Kabuto, Y.; Morihara, T.; Sukenari, T.; Kida, Y.; Oda, R.; Arai, Y.; Sawada, K.; Matsuda, K.; Kawata, M.; Tabata, Y.; et al. Stimulation of rotator cuff repair by sustained release of bone morphogenetic protein-7 using a gelatin hydrogel sheet. Tissue Eng. Part A 2015, 21, 2025–2033. [Google Scholar] [CrossRef]
- Rinoldi, C.; Fallahi, A.; Yazdi, I.K.; Campos Paras, J.; Kijeńska-Gawrońska, E.; Trujillo-de Santiago, G.; Tuoheti, A.; Demarchi, D.; Annabi, N.; Khademhosseini, A.; et al. Mechanical and Biochemical Stimulation of 3D Multilayered Scaffolds for Tendon Tissue Engineering. ACS Biomater. Sci. Eng. 2019, 5, 2953–2964. [Google Scholar] [CrossRef]
- Kim, J.H.; Kim, T.H.; Kang, M.S.; Kim, H.W. Angiogenic Effects of Collagen/Mesoporous Nanoparticle Composite Scaffold Delivering VEGF165. Biomed Res. Int. 2016, 2016, 9676934. [Google Scholar] [CrossRef] [PubMed]
- Li, M.; Chen, Y.; Hu, J.; Shi, Q.; Li, X.; Zhao, C.; Chen, C.; Lu, H. Sustained release of collagen-affinity SDF-1α from book-shaped acellular fibrocartilage scaffold enhanced bone-tendon healing in a rabbit model. J. Orthop. Res. 2021, 39, 1331–1343. [Google Scholar] [CrossRef] [PubMed]
- Xu, W.; Wang, Y.; Liu, E.; Sun, Y.; Luo, Z.; Xu, Z.; Liu, W.; Zhong, L.; Lv, Y.; Wang, A.; et al. Human iPSC-derived neural crest stem cells promote tendon repair in a rat patellar tendon window defect model. Tissue Eng. Part A 2013, 19, 2439–2451. [Google Scholar] [CrossRef] [PubMed]
- Yoon, J.P.; Lee, C.H.; Jung, J.W.; Lee, H.J.; Lee, Y.S.; Kim, J.Y.; Park, G.Y.; Choi, J.H.; Chung, S.W. Sustained Delivery of Transforming Growth Factor β1 by Use of Absorbable Alginate Scaffold Enhances Rotator Cuff Healing in a Rabbit Model. Am. J. Sports Med. 2018, 46, 1441–1450. [Google Scholar] [CrossRef] [PubMed]
- Reifenrath, J.; Wellmann, M.; Kempfert, M.; Angrisani, N.; Welke, B.; Gniesmer, S.; Kampmann, A.; Menzel, H.; Willbold, E. TGF–β3 loaded electrospun polycaprolacton fibre scaffolds for rotator cuff tear repair: An in vivo study in rats. Int. J. Mol. Sci. 2020, 21, 1046. [Google Scholar] [CrossRef]
- Volova, T.; Goncharov, D.; Sukovatyi, A.; Shabanov, A.; Nikolaeva, E.; Shishatskaya, E. Electrospinning of polyhydroxyalkanoate fibrous scaffolds: Effects on electrospinning parameters on structure and properties. J. Biomater. Sci. Polym. Ed. 2014, 25, 370–393. [Google Scholar] [CrossRef]
- Sombatmankhong, K.; Suwantong, O.; Waleetorncheepsawat, S.; Supaphol, P. Electrospun Fiber Mats of Poly(3-Hydroxybutyrate), Poly(3-Hydroxybutyrate-co-3-Hydroxyvalerate), and Their Blends. Polym. Sci. 2006, 44, 2923–2933. [Google Scholar] [CrossRef]
- Sombatmankhong, K.; Sanchavanakit, N.; Pavasant, P.; Supaphol, P. Bone scaffolds from electrospun fiber mats of poly(3-hydroxybutyrate), poly(3-hydroxybutyrate-co-3-hydroxyvalerate) and their blend. Polymer 2007, 48, 1419–1427. [Google Scholar] [CrossRef]
- Chen, W.; Li, Y.; Huang, Y.; Dai, Y.; Xi, T.; Zhou, Z.; Liu, H. Quercetin modified electrospun PHBV fibrous scaffold enhances cartilage regeneration. J. Mater. Sci. Mater. Med. 2021, 32, 92. [Google Scholar] [CrossRef]
- Toncheva, A.; Mincheva, R.; Kancheva, M.; Manolova, N.; Rashkov, I.; Dubois, P.; Markova, N. Antibacterial PLA/PEG electrospun fibers: Comparative study between grafting and blending PEG. Eur. Polym. J. 2016, 75, 223–233. [Google Scholar] [CrossRef]
- Huang, T.Y.; Shahrousvand, M.; Hsu, Y.T.; Su, W.T. Polycaprolactone/Polyethylene glycol blended with dipsacus asper wall extract nanofibers promote osteogenic differentiation of periodontal ligament stem cells. Polymers 2021, 13, 2245. [Google Scholar] [CrossRef]
- Rashid, M.; Dudhia, J.; Dakin, S.G.; Snelling, S.J.B.; De Godoy, R.; Mouthuy, P.A.; Smith, R.K.W.; Morrey, M.; Carr, A.J. Histopathological and immunohistochemical evaluation of cellular response to a woven and electrospun polydioxanone (PDO) and polycaprolactone (PCL) patch for tendon repair. Sci. Rep. 2020, 10, 4754. [Google Scholar] [CrossRef] [PubMed]
- Touré, A.B.R.; Mele, E.; Christie, J.K. Multi-layer scaffolds of Poly(Caprolactone), Poly(glycerol sebacate) and bioactive glasses manufactured by combined 3D Printing and Electrospinning. Nanomaterials 2020, 10, 626. [Google Scholar] [CrossRef] [PubMed]
- Zhao, T.; Qi, Y.; Xiao, S.; Ran, J.; Wang, J.; Ghamor-Amegavi, E.P.; Zhou, X.; Li, H.; He, T.; Gou, Z.; et al. Integration of mesenchymal stem cell sheet and bFGF-loaded fibrin gel in knitted PLGA scaffolds favorable for tendon repair. J. Mater. Chem. B 2019, 7, 2201–2211. [Google Scholar] [CrossRef] [PubMed]
- Majima, T.; Irie, T.; Sawaguchi, N.; Funakoshi, T.; Iwasaki, N.; Harada, K.; Minami, A.; Nishimura, S.I. Chitosan-based hyaluronan hybrid polymer fibre scaffold for ligament and tendon tissue engineering. Proc. Inst. Mech. Eng. Part H J. Eng. Med. 2007, 221, 537–546. [Google Scholar] [CrossRef]
- Guner, M.B.; Dalgic, A.D.; Tezcaner, A.; Yilanci, S.; Keskin, D. A dual-phase scaffold produced by rotary jet spinning and electrospinning for tendon tissue engineering. Biomed. Mater. 2020, 15, 065014. [Google Scholar] [CrossRef]

| Methods for tendon repair | Advantages | Disadvantages | References |
|---|---|---|---|
| Conservative treatment | |||
| Extracorporeal shock wave therapy | Safe Simple to apply | Mechanism not fully understood The effects on healing are unclear | [40,41] |
| Ultrasound | Safe Simple to apply Short-term pain relief Adhesion prevention Reduction in the amount of inflammatory infiltrate | Mechanism not fully understood The effects on healing are unclear Too high-intensity ultrasound can have tissue destructive effects Cannot be used as a sole treatment, always used as a complement | [42,43] |
| Exercise | Decreased tendon volume Increased synthesis of type I collagen Improved tendon gliding and repair strength Adhesion prevention | Risk of re-injuring Most appropriate exercises for each type of injury are unknown | [44,45] |
| Surgical intervention | Alternative when other techniques have not worked or in cases of total tendon rupture Remove the damaged part of the tendon | Loss of tissue mechanical properties Generation of scar tissue or adhesions Unable to regenerate completely the injured tissue Risk of damage and infection | [46,47] |
| NSAIDs | Short-term analgesic effect | The effects on healing are unclear Negative effects when given postoperatively: decrease failure loads and increased rates of failure Gastrointestinal, cardiovascular and renal risks | [48,49,50] |
| Growth factors | Simplicity of the injection Well-studied targets Demonstrated effect on tendon regeneration Increasing load to failure and elongation values, stimulating collagen and matrix production, inducing tenocyte differentiation and tendon specific gene markers, inducing cell proliferation, etc. | Short half-life in the damaged tendon (requires repeated injections) Costly Little knowledge about the dosage and timing of injection | [44,51] |
| Cell therapy | Demonstrated effect on tendon regeneration Improved clinical outcome scores, improved biomechanical testing, increased collagen production and alignment, etc. | Difficult to maintain the cells at the specific site of injury Risk of unleashing an immune response | [52,53] |
| Gene therapy | Sustained and targeted production of growth factors and additional molecules Can avoid immunogenicity | Expensive Complicated manufacturing processes Poorly developed technique | [44,54] |
| Solution Parameters | Process Parameters | Environmental Parameters |
|---|---|---|
| Polymer(s) molecular weight | Coagulation bath (non-solvent) | Drying temperature |
| Polymer(s) concentration | Coagulation bath temperature | Humidity |
| Viscosity | Needle diameter | |
| Solvent | Flow rate | |
| Washing bath | ||
| Dewatering bath |
| Polymers | Solvent/Mix of Solvents | Wetspinning Parameters | Application Perspective | Ref. |
|---|---|---|---|---|
| Polyhydroxybutyrate—98%/polyhydroxyvalerate 2% (PHBV) | Chloroform 20% (w/v) | Flow rate: 0.2 mL/min Coagulation bath: ethanol | Tissue Engineering | [75] |
| PHBV-O2-ELR-REDV (PHBV (HV content 8% w/v)) | Chloroform 8% (w/v) | Flow rate: 1 mL/h Coagulation bath: methanol | Tissue Engineering | [76] |
| PHBHHx/PCL (12% w/v) PHBHHx/PCL weight ratios (3:1, 2:1 and 1:1) | Tetrahydrofuran (THF) | Coagulation bath: ethanol | Tissue Engineering | [83] |
| PHBHHx (25% w/v) | Chloroform | Flow rate: 0.2 mL/h Coagulation bath: ethanol | Tissue Engineering | [84] |
| Polymers | Solvent/Mix of solvents | Wetspinning Parameters | Application Perspective | Ref. |
|---|---|---|---|---|
| PCL (10% (w/v) | Chloroform/tetrahydrofuran (3:1, v/v) | Flow rate: 1, 4, and 8 mL/h Coagulation bath: edible oil/hexane solution (3:1, v/v) | Tissue Engineering | [88] |
| PCL (6–20% w/v) | Acetone | Coagulation bath: methanol | Tissue Engineering | [89] |
| PCL (10–20% w/v) loaded with HNPs, CD or CD–HNP | Acetone Chloroform | Flow rate: 1.5–3.5 mL/h Coagulation bath: methanol, ethanol, water | Tissue Engineering and Regenerative Medicine | [90] |
| PCL (15% w/v) | Acetone | Flow rate: 2.25 mL/h Coagulation bath: ethanol | Tissue Engineering | [22] |
| CHT/PCL (100:0, 75:25, 50:50) | Formic acid (100 vol.%) | Coagulation bath: methanol | Tissue Engineering | [91] |
| PCL/gelatin (70:30) PCL/gelatin/HAp | PCL: formic acid/acetic acid (3:1 v/v) Gelatin: 80% acetic | Coagulation bath: glutaraldehyde/water (1.25% (v/v)) Flow rates: 0.25, 0.5 and 1 mL/h | Tissue Engineering | [58] |
| Polymers | Solvent/Mix of Solvents | Wetspinning Parameters | Application Perspective | Ref. |
|---|---|---|---|---|
| Collagen I/PEG 4000 (3.25 wt%) | Acetic Acid | Flow rate: 0.01–5 mL/min Coagulation bath: 10% (w/v) PEG 20,000, 6.86 mg/mL TES, 4.14 mg/mL NaH2PO4, 7.89 mg/mL NaCl and 12.10 mg/mL Na2HPO4 | Tissue Engineering | [98] |
| CNC-g-PEGX (X refers to the molecular weight of PEG)/sodium alginate (4 wt%) | Water | Coagulation bath: calcium chloride | Medical Textiles | [107] |
| Collagen (0.8–1.6% wt/vol) Crosslinked with PEG | Acetic Acid | Flow rate: 12 mL/h Coagulation bath: ethanol | Tissue Engineering | [108] |
| CHI/PSS-PEO (5 wt%) | --- | Washing bath: 50:50 mixture of water and ethanol | Tissue Engineering | [106] |
| Growth Factor | Injury | Main Results | Ref. |
|---|---|---|---|
| PDGF-BB | Achilles tendon full laceration | Increased tensile stress, failure stress, stiffness, and elastic modulus of treated tendons Upregulated expression of collagen I and III Thickening and enlargement of the cross-sectional area of the tendons Decreased cellularity | [125] |
| IGF-1 | General tendon injury | Increased cellularity Increased collagen synthesis in TDSC Glycosaminoglycan synthesis | [126] |
| BMP-7 | Rotator Cuff tear | Favorable orientation of rotator cuff collagen fibers Helps tendon-to-bone maturing Improves the ultimate force-to-failure | [127] |
| BMP-12 | General tendon injury | Increased cell proliferation Upregulated expression of key tenogenic markers (collagen I, tenomodulin, scleraxis, TN-C) | [128] |
| bFGF | Achilles tendon defect | Increased tendon- related gene expression Improvement of the biomechanical strength Stimulate MSCs tenogenic differentiation | [131] |
| Mat | Young’s Modulus (MPa) | Breaking Load (MPa) | Maximum Deformation (%) |
|---|---|---|---|
| PLA | 94 ± 8 | 3.9 ± 0.03 | 56 ± 7 |
| PLA/PEG400 | 150 ± 19 | 1.5 ± 0.02 | 35 ± 4 |
| PLA/PEG2000 | 131 ± 16 | 0.8 ± 0.03 | 40 ± 5 |
| PLA-g-poly(acrylIPEG) | 155 ± 18 | 1.4 ± 0.02 | 4.6 ± 0.4 |
| PLA/5N8Q | 65 ± 5 | 3.0 ± 0.06 | 50 ± 8 |
| PLA/ PEG400/5N8Q | 83 ± 6 | 0.8 ± 0.08 | 21 ± 2 |
| PLA/ PEG2000/5N8Q | 88 ± 7 | 0.6 ± 0.04 | 25 ± 3 |
| PLA-g-poly(acrylIPEG)/5N8Q | 105 ± 13 | 0.8 ± 0.03 | 3.7 ± 0.3 |
Publisher’s Note: MDPI stays neutral with regard to jurisdictional claims in published maps and institutional affiliations. |
© 2022 by the authors. Licensee MDPI, Basel, Switzerland. This article is an open access article distributed under the terms and conditions of the Creative Commons Attribution (CC BY) license (https://creativecommons.org/licenses/by/4.0/).
Share and Cite
Rocha, J.; Araújo, J.C.; Fangueiro, R.; Ferreira, D.P. Wetspun Polymeric Fibrous Systems as Potential Scaffolds for Tendon and Ligament Repair, Healing and Regeneration. Pharmaceutics 2022, 14, 2526. https://doi.org/10.3390/pharmaceutics14112526
Rocha J, Araújo JC, Fangueiro R, Ferreira DP. Wetspun Polymeric Fibrous Systems as Potential Scaffolds for Tendon and Ligament Repair, Healing and Regeneration. Pharmaceutics. 2022; 14(11):2526. https://doi.org/10.3390/pharmaceutics14112526
Chicago/Turabian StyleRocha, Joana, Joana C. Araújo, Raul Fangueiro, and Diana P. Ferreira. 2022. "Wetspun Polymeric Fibrous Systems as Potential Scaffolds for Tendon and Ligament Repair, Healing and Regeneration" Pharmaceutics 14, no. 11: 2526. https://doi.org/10.3390/pharmaceutics14112526
APA StyleRocha, J., Araújo, J. C., Fangueiro, R., & Ferreira, D. P. (2022). Wetspun Polymeric Fibrous Systems as Potential Scaffolds for Tendon and Ligament Repair, Healing and Regeneration. Pharmaceutics, 14(11), 2526. https://doi.org/10.3390/pharmaceutics14112526

